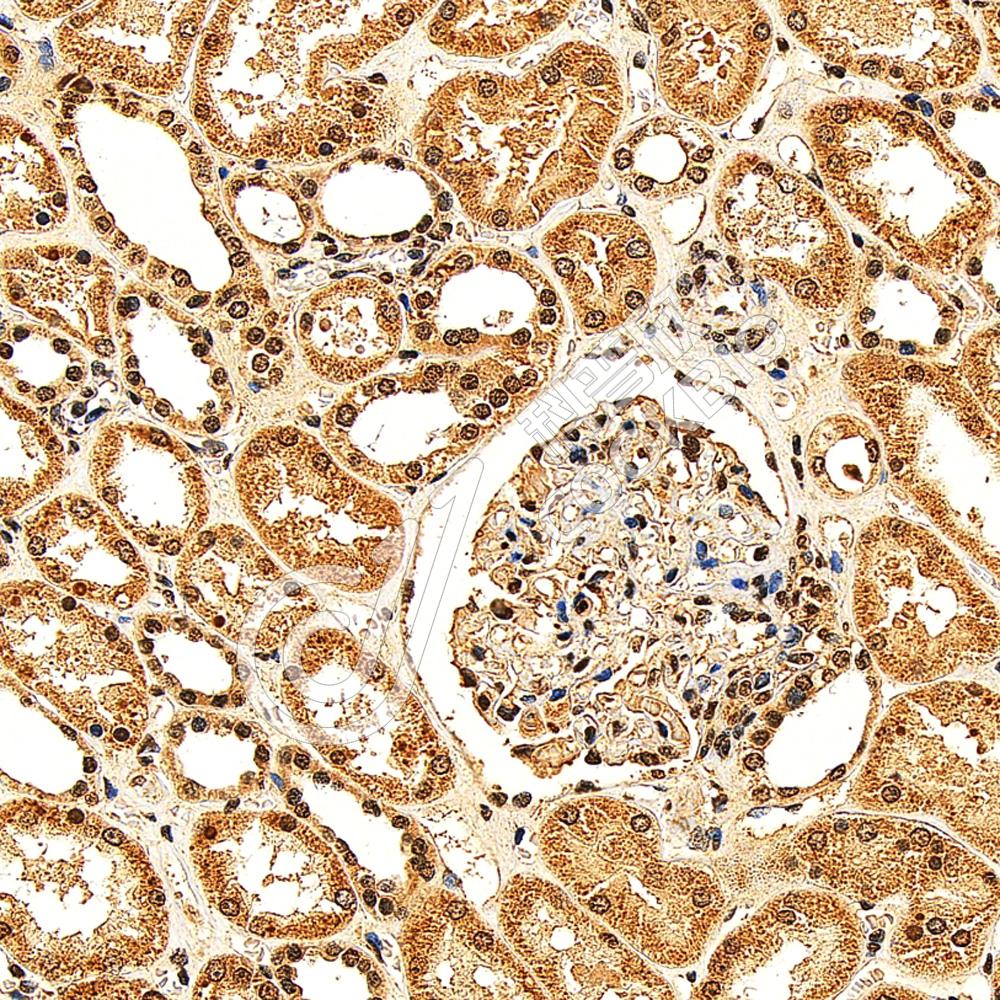

产品信息
| 蛋白质全称 | 同源框蛋白Hox-D11 |
|---|---|
| 别名 | homeobox D11,Homeobox protein Hox 4F,Homeobox protein Hox D11,HOX4,HOX4F,HOXD11 |
| Uniprot ID | P23813 |
| 免疫原 | KLH偶联的小鼠HOXD11合成肽 |
| 抗体亚型 | IgG |
| 纯化方式 | 亲和纯化 |
| 亚细胞定位 | 细胞核 |
应用
IHC/IF 免疫组织化学/免疫荧光
物种:人,小鼠,大鼠
稀释比:1:500-1:2000
阳性样品:食管, 心, 肾
背景
Sequence-specific transcription factor which is part of a developmental regulatory system that provides cells with specific positional identities on the anterior-posterior axis.
储存条件
储存条件:储存条件在:-20℃下储存一年, 避免反复冻融.
储存缓冲液:含0.15% ProClin300防腐剂, 100 μg/mL牛血清白蛋白和50%甘油的磷酸盐缓冲液.
图像

IHC检测HOXD11蛋白(货号 K1345186).
样品: 人食管, 4%多聚甲醛 (货号KSG1101) 固定12-24小时.
抗原修复: Tris-EDTA抗原修复液(pH 9.0) (KSG1203), 98℃, 20分钟.
—抗: 1: 1300稀释, 4℃ 孵育过夜.
二抗: S-vision免疫组化多聚二抗(山羊抗兔),即用型 (货号KB3906), 室温孵育20分钟.
样品: 人食管, 4%多聚甲醛 (货号KSG1101) 固定12-24小时.
抗原修复: Tris-EDTA抗原修复液(pH 9.0) (KSG1203), 98℃, 20分钟.
—抗: 1: 1300稀释, 4℃ 孵育过夜.
二抗: S-vision免疫组化多聚二抗(山羊抗兔),即用型 (货号KB3906), 室温孵育20分钟.
IHC检测HOXD11蛋白(货号 K1345186).
样品: 人肾, 4%多聚甲醛 (货号KSG1101) 固定12-24小时.
抗原修复: Tris-EDTA抗原修复液(pH 9.0) (KSG1203), 98℃, 20分钟.
—抗: 1: 1300稀释, 4℃ 孵育过夜.
二抗: S-vision免疫组化多聚二抗(山羊抗兔),即用型 (货号KB3906), 室温孵育20分钟.
样品: 人肾, 4%多聚甲醛 (货号KSG1101) 固定12-24小时.
抗原修复: Tris-EDTA抗原修复液(pH 9.0) (KSG1203), 98℃, 20分钟.
—抗: 1: 1300稀释, 4℃ 孵育过夜.
二抗: S-vision免疫组化多聚二抗(山羊抗兔),即用型 (货号KB3906), 室温孵育20分钟.

IHC检测HOXD11蛋白(货号 K1345186).
样品: 小鼠心, 4%多聚甲醛 (货号KSG1101) 固定12-24小时.
抗原修复: Tris-EDTA抗原修复液(pH 9.0) (KSG1203), 98℃, 20分钟.
—抗: 1: 1300稀释, 4℃ 孵育过夜.
二抗: S-vision免疫组化多聚二抗(山羊抗兔),即用型 (货号KB3906), 室温孵育20分钟.
样品: 小鼠心, 4%多聚甲醛 (货号KSG1101) 固定12-24小时.
抗原修复: Tris-EDTA抗原修复液(pH 9.0) (KSG1203), 98℃, 20分钟.
—抗: 1: 1300稀释, 4℃ 孵育过夜.
二抗: S-vision免疫组化多聚二抗(山羊抗兔),即用型 (货号KB3906), 室温孵育20分钟.

IHC检测HOXD11蛋白(货号 K1345186).
样品: 大鼠肺, 4%多聚甲醛 (货号KSG1101) 固定12-24小时.
抗原修复: Tris-EDTA抗原修复液(pH 9.0) (KSG1203), 98℃, 20分钟.
—抗: 1: 1300稀释, 4℃ 孵育过夜.
二抗: S-vision免疫组化多聚二抗(山羊抗兔),即用型 (货号KB3906), 室温孵育20分钟.
样品: 大鼠肺, 4%多聚甲醛 (货号KSG1101) 固定12-24小时.
抗原修复: Tris-EDTA抗原修复液(pH 9.0) (KSG1203), 98℃, 20分钟.
—抗: 1: 1300稀释, 4℃ 孵育过夜.
二抗: S-vision免疫组化多聚二抗(山羊抗兔),即用型 (货号KB3906), 室温孵育20分钟.
需要技术支持?
如果您有任何问题或如果您在实验过程中遇到问题,或需要更详细的技术指导,请联系我们的技术支持团队
 400-6027-270
400-6027-270
联系我们
如果您对我们的公司或产品有任何疑问,欢迎随时联系我们





















 湖北省武汉市东湖新技术开发区高新二路388号生物医药加速器22栋5楼
湖北省武汉市东湖新技术开发区高新二路388号生物医药加速器22栋5楼  400-6027-270
400-6027-270  鄂公网安备42018502008544号
鄂公网安备42018502008544号